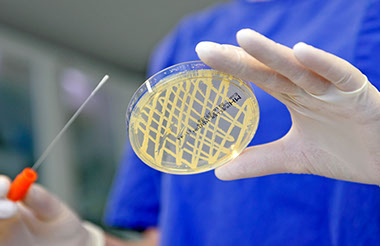

Mobil 0151 15667711
Tierärztin Dr. med. vet. Katrin Fee Gohr
Kornmoor 8 · 28870 Ottersberg Ortsteil: Fischerhude-Quelkhorn
E-Mail: praxis@kornmoor.de
Sprechzeiten nach Ihren Wünschen
Fundierte Diagnostik
Schnelle Untersuchungsergebnisse helfen bei der Diagnostik, damit es ihren kleinen Lieblingen bald wieder besser geht.